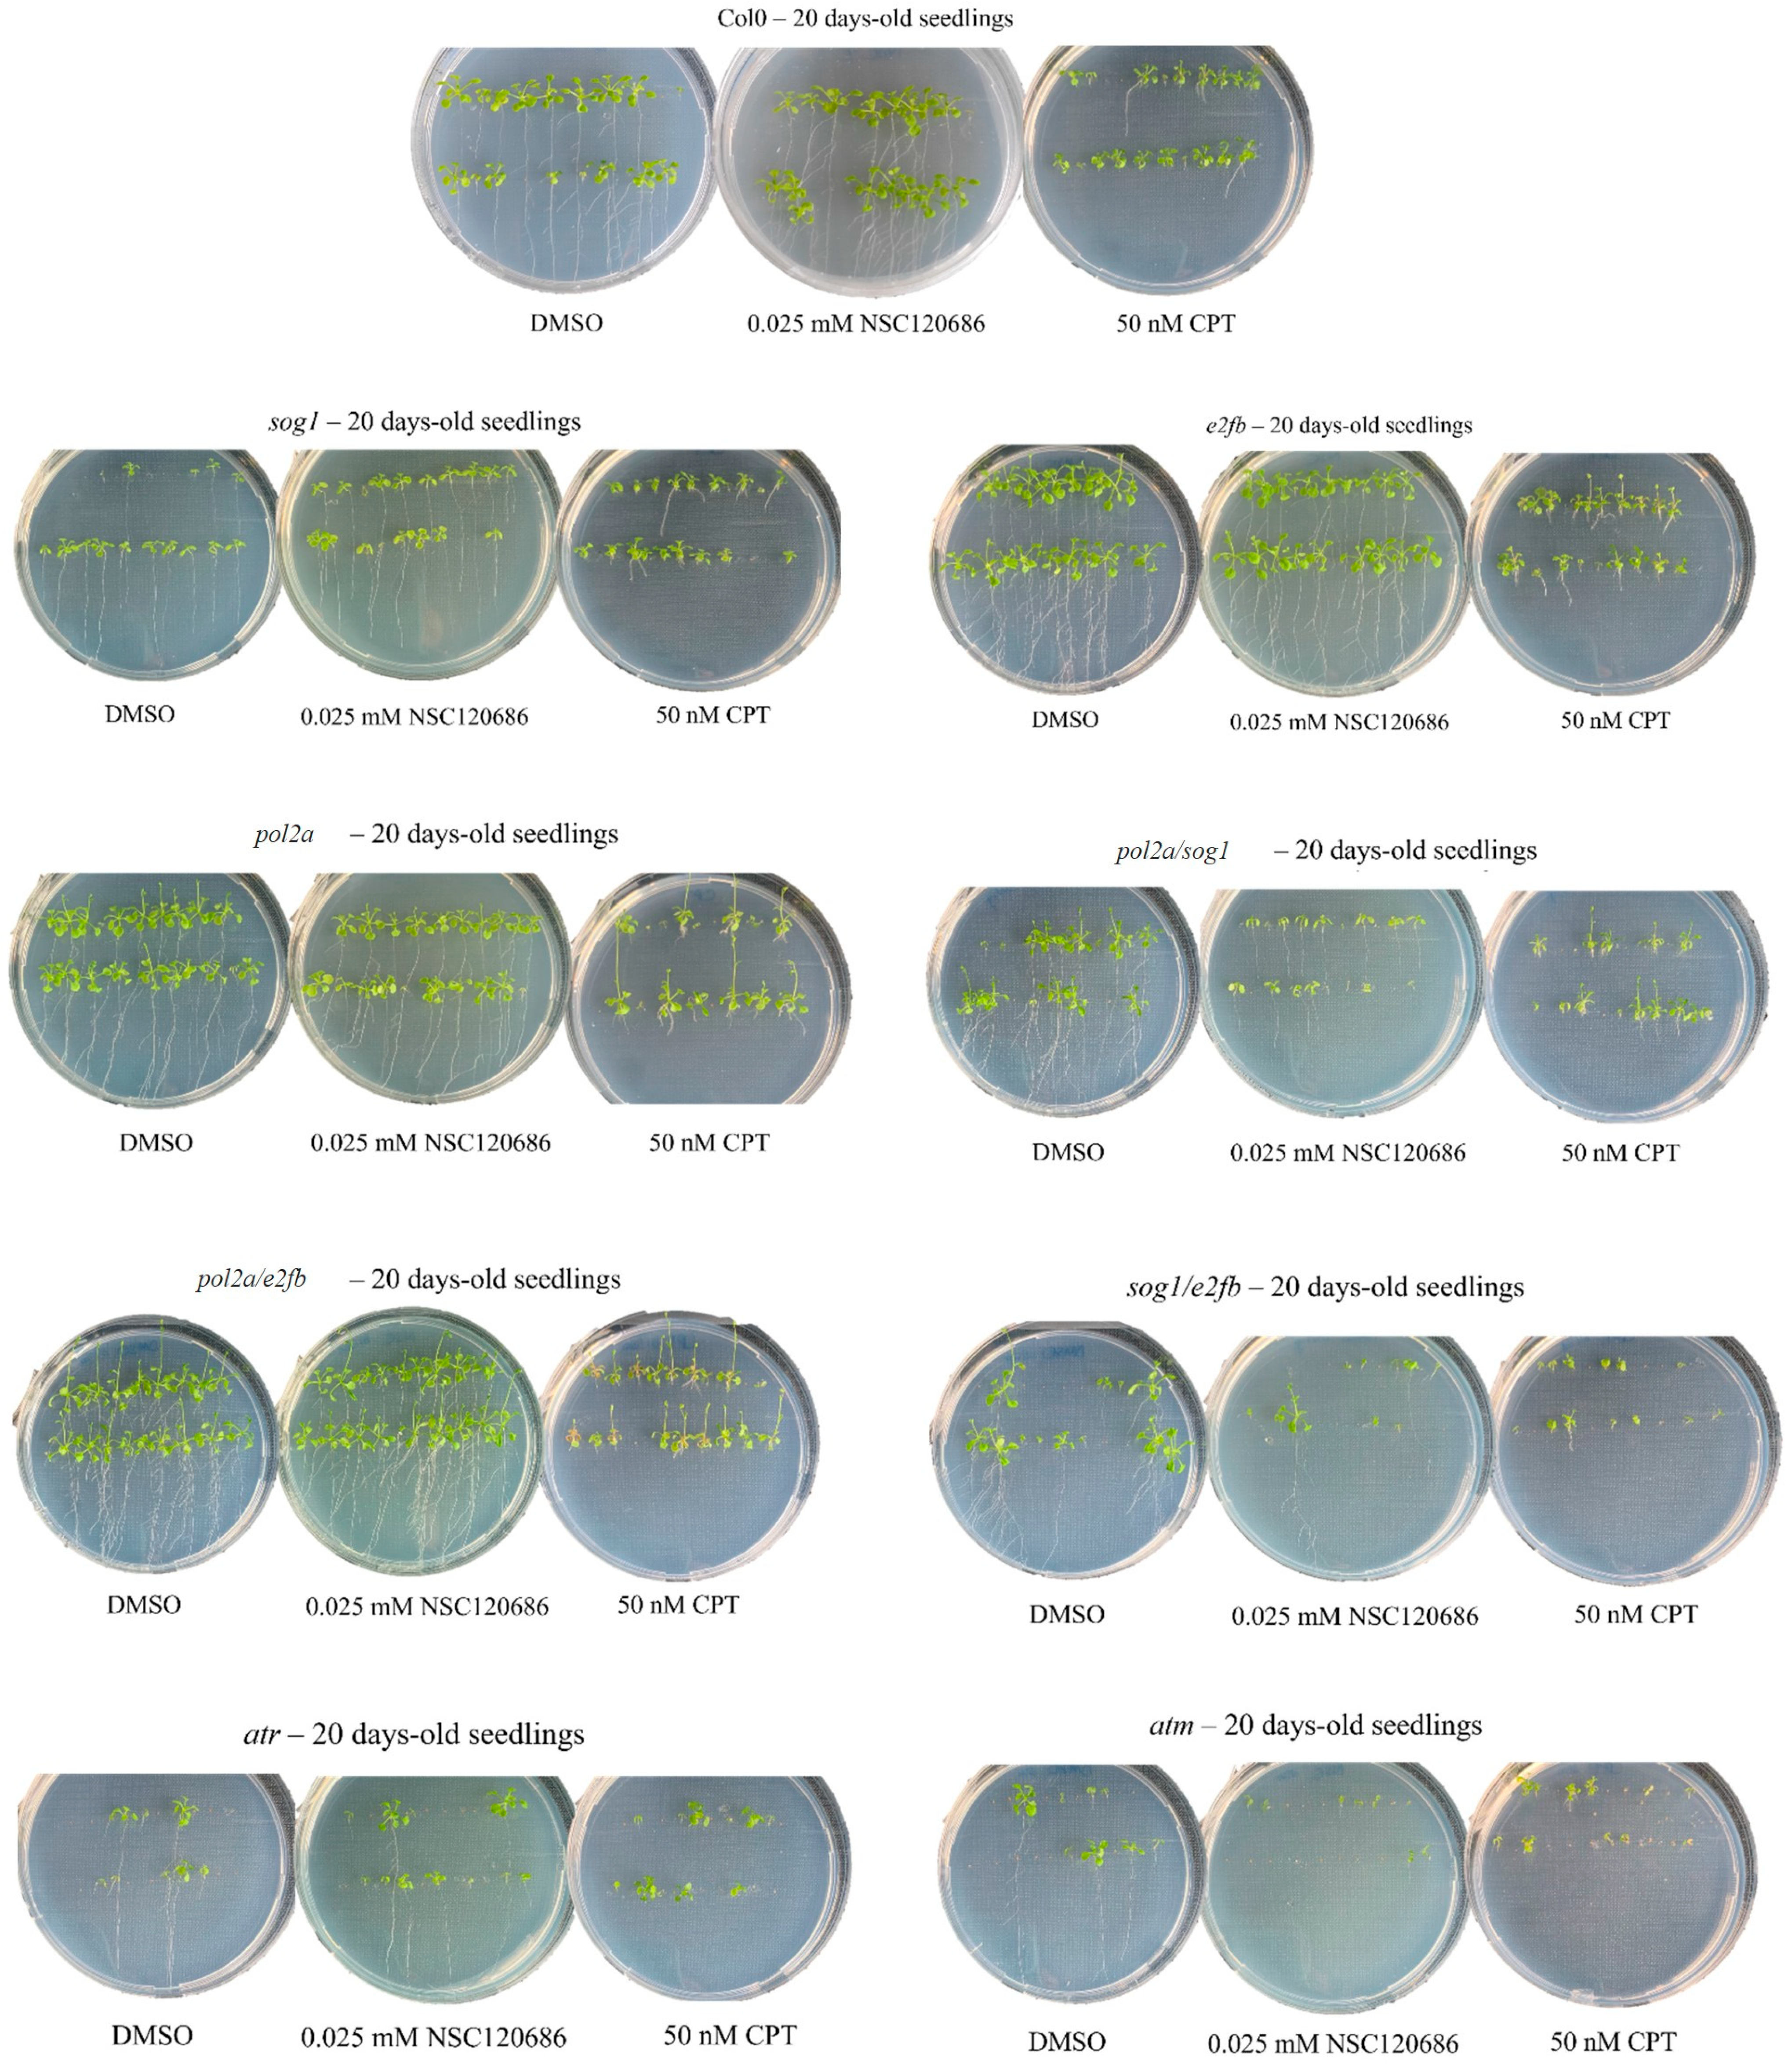
Genes 16 00103 g003 Genes 16 00103 g003

Arabidopsis thaliana DNA Damage Response Mutants Challenged with Genotoxic Agents—A Different Experimental Approach to Investigate the TDP1α and TDP1β Genes
Abstract
1. Introduction
2. Materials and Methods
2.1. Plant Material and Treatments
2.2. Plant Phenotyping Analyses
2.3. RNA Extraction and cDNA Synthesis
2.4. Quantitative Real-Time PCR (qRT-PCR)
2.5. Statistical Analyses
3. Results
3.1. Germination Is Affected in the Mutants but Not in Response to Stress
3.2. Changes in the Plant Growth Patterns Are Caused by Genotoxic Treatments
3.3. The Expression of TDP1α and TDP1βGenes Is Influenced by Both Genotype and Treatments
4. Discussion
5. Conclusions
Author Contributions
Funding
Institutional Review Board Statement
Informed Consent Statement
Data Availability Statement
Acknowledgments
Conflicts of Interest
References
- Andresen, E.; Küpper, H. Cadmium toxicity in plants. Met. Ions Life Sci. 2013, 11, 395–413. [Google Scholar] [PubMed]
- Fuchs, L.K.; Jenkins, G.; Phillips, D.W. Anthropogenic impacts on meiosis in plants. Front. Plant Sci. 2018, 9, 1429. [Google Scholar] [CrossRef]
- Kosakivska, I.V.; Babenko, L.M.; Romanenko, K.O.; Korotka, I.Y.; Potters, G. Molecular mechanisms of plant adaptive responses to heavy metals stress. Cell Biol. Int. 2021, 45, 258–272. [Google Scholar] [CrossRef] [PubMed]
- Haider, F.U.; Zulfiqar, U.; Ain, N.U.; Mehmood, T.; Ali, U.; Ramos Aguila, L.C.; Li, Y.; Siddique, K.H.M.; Farooq, M. Managing antimony pollution: Insights into Soil-Plant system dynamics and remediation Strategies. Chemosphere 2024, 362, 142694. [Google Scholar] [CrossRef] [PubMed]
- Zaidi, S.; Hayat, S.; Pichtel, J. Arsenic-induced plant stress: Mitigation strategies and omics approaches to alleviate toxicity. Plant Physiol. Biochem. 2024, 213, 108811. [Google Scholar] [CrossRef] [PubMed]
- Manova, V.; Gruszka, D. DNA damage and repair in plants—From models to crops. Front. Plant Sci. 2015, 6, 885. [Google Scholar] [CrossRef] [PubMed]
- Georgieva, K.; Dagnon, S.; Gesheva, E.; Bojilov, D.; Mihailova, G.; Doncheva, S. Antioxidant defense during desiccation of the resurrection plant Haberlea rhodopensis. Plant Physiol. Biochem. 2017, 114, 51–59. [Google Scholar] [CrossRef] [PubMed]
- Dutta, S.; Mitra, M.; Agarwal, P.; Mahapatra, K.; De, S.; Sett, U.; Roy, S. Oxidative and genotoxic damages in plants in response to heavy metal stress and maintenance of genome stability. Plant Signal. Behav. 2018, 13, e1460048. [Google Scholar] [CrossRef]
- Ghosh, M.; Ghosh, I.; Godderis, L.; Hoet, P.; Mukherjee, A. Genotoxicity of engineered nanoparticles in higher plants. Mutat. Res. Genet. Toxicol. Environ. Mutagen. 2019, 842, 132–145. [Google Scholar] [CrossRef] [PubMed]
- Tuteja, N.; Singh, M.B.; Misra, M.K.; Bhalla, P.L.; Tuteja, R. Molecular mechanisms of DNA damage and repair: Progress in plants. Crit. Rev. Biochem. Mol. Biol. 2001, 36, 337–397. [Google Scholar] [CrossRef] [PubMed]
- Spampinato, C.P. Protecting DNA from errors and damage: An overview of DNA repair mechanisms in plants compared to mammals. Cell. Mol. Life Sci. 2017, 74, 1693–1709. [Google Scholar] [CrossRef] [PubMed]
- Raina, A.; Sahu, P.K.; Laskar, R.A.; Rajora, N.; Sao, R.; Khan, S.; Ganai, R.A. Mechanisms of genome maintenance in plants: Playing it safe with breaks and bumps. Front. Genet. 2021, 12, 675686. [Google Scholar] [CrossRef]
- Georgieva, M.; Vassileva, V. Stress management in plants: Examining provisional and unique dose-dependent responses. Int. J. Mol. Sci. 2023, 24, 5105. [Google Scholar] [CrossRef] [PubMed]
- Yoshiyama, K.O.; Sakaguchi, K.; Kimura, S. DNA damage response in plants: Conserved and variable response compared to animals. Biology 2013, 2, 1338–1356. [Google Scholar] [CrossRef] [PubMed]
- Nisa, M.U.; Huang, Y.; Benhamed, M.; Raynaud, C. The plant DNA damage response: Signaling pathways leading to growth inhibition and putative role in response to stress conditions. Front. Plant Sci. 2019, 10, 653. [Google Scholar] [CrossRef]
- Gentric, N.; Genschik, P.; Noir, S. Connections between the cell cycle and the DNA damage response in plants. Int. J. Mol. Sci. 2021, 17, 9558. [Google Scholar] [CrossRef] [PubMed]
- Szurman-Zubrzycka, M.; Jędrzejek, P.; Szarejko, I. How do plants cope with DNA damage? A concise review on the DDR pathway in plants. Int. J. Mol. Sci. 2023, 24, 2404. [Google Scholar] [CrossRef] [PubMed]
- Garcia, V.; Bruchet, H.; Camescasse, D.; Granier, F.; Bouchez, D.; Tissier, A. AtATM is essential for meiosis and the somatic response to DNA damage in plants. Plant Cell 2003, 15, 119–132. [Google Scholar] [CrossRef]
- Culligan, K.; Tissier, A.; Britt, A. ATR regulates a G2-phase cell-cycle checkpoint in Arabidopsis thaliana. Plant Cell 2004, 16, 1091–1104. [Google Scholar] [CrossRef] [PubMed]
- Pedroza-García, J.A.; Mazubert, C.; Del Olmo, I.; Bourge, M.; Domenichini, S.; Bounon, R.; Tariq, Z.; Delannoy, E.; Piñeiro, M.; Jarillo, J.A.; et al. Function of the plant DNA polymerase epsilon in replicative stress sensing, a genetic analysis. Plant Physiol. 2017, 173, 1735–1749. [Google Scholar] [CrossRef]
- Yoshiyama, K.O.; Conklin, P.A.; Huefner, N.D.; Britt, A.B. Suppressor of gamma response 1 (SOG1) encodes a putative transcription factor governing multiple responses to DNA damage. Proc. Natl. Acad. Sci. USA 2009, 106, 12843–12848. [Google Scholar] [CrossRef] [PubMed]
- Bourbousse, C.; Vegesna, N.; Law, J.A. SOG1 activator and MYB3R repressors regulate a complex DNA damage network in Arabidopsis. Proc. Natl. Acad. Sci. USA 2018, 52, E12453–E12462. [Google Scholar] [CrossRef] [PubMed]
- Preuss, S.B.; Britt, A.B. A DNA-damage-induced cell cycle checkpoint in Arabidopsis. Genetics 2003, 164, 323–334. [Google Scholar] [CrossRef] [PubMed]
- Pedroza-Garcia, J.A.; Xiang, Y.; De Veylder, L. Cell cycle checkpoint control in response to DNA damage by environmental stresses. Plant J. 2022, 109, 490–507. [Google Scholar] [CrossRef] [PubMed]
- Hu, Z.; Cools, T.; Kalhorzadeh, P.; Heyman, J.; De Veylder, L. Deficiency of the Arabidopsis helicase RTEL1 triggers a SOG1-dependent replication checkpoint in response to DNA cross-links. Plant Cell 2015, 27, 149–161. [Google Scholar] [CrossRef] [PubMed]
- Nisa, M.; Eekhout, T.; Bergis, C.; Pedroza-Garcia, J.A.; He, X.; Mazubert, C.; Vercauteren, I.; Cools, T.; Brik-Chaouche, R.; Drouin-Wahbi, J.; et al. Distinctive and complementary roles of E2F transcription factors during plant replication stress responses. Mol. Plant. 2023, 16, 1269–1282. [Google Scholar] [CrossRef] [PubMed]
- Donà, M.; Confalonieri, M.; Minio, A.; Biggiogera, M.; Buttafava, A.; Raimondi, E.; Delledonne, M.; Ventura, L.; Sabatini, M.E.; Macovei, A.; et al. RNA-Seq analysis discloses early senescence and nucleolar dysfunction triggered by Tdp1α depletion in Medicago truncatula. J. Exp. Bot. 2013, 64, 1941–1951. [Google Scholar] [CrossRef]
- Enderle, J.; Dorn, A.; Puchta, H. DNA- and DNA-protein-crosslink repair in plants. Int. J. Mol. Sci. 2019, 20, 4304. [Google Scholar] [CrossRef] [PubMed]
- Hacker, L.; Dorn, A.; Puchta, H. Repair of DNA-protein crosslinks in plants. DNA Repair (Amst.) 2020, 87, 102787. [Google Scholar] [CrossRef]
- Pouliot, J.J. Yeast gene for a tyr-DNA phosphodiesterase that repairs topoisomerase I complexes. Science 1999, 286, 552–555. [Google Scholar] [CrossRef] [PubMed]
- Pommier, Y. Topoisomerase I inhibitors: Camptothecins and beyond. Nat. Rev. Cancer 2006, 10, 789–802. [Google Scholar] [CrossRef]
- Macovei, A.; Balestrazzi, A.; Confalonieri, M.; Carbonera, D. The tyrosyl-DNA phosphodiesterase gene family in Medicago truncatula Gaertn.: Bioinformatics investigation and expression profiles in response to copper-and PEG-mediated stress. Planta 2010, 232, 393–407. [Google Scholar] [CrossRef] [PubMed]
- Sabatini, M.E.; Donà, M.; Leonetti, P.; Minio, A.; Delledonne, M.; Carboneral, D.; Confalonieri, M.; Giraffa, G.; Balestrazzi, A. Depletion of Tyrosyl- DNA Phosphodiesterase 1α (MtTdp1α) affects transposon expression in Medicago Truncatula. J. Integr. Plant Biol. 2016, 58, 618–622. [Google Scholar] [CrossRef]
- Enderle, J.; Dorn, A.; Beying, N.; Trapp, O.; Puchta, H. The protease WSS1A, the endonuclease MUS81, and the phosphodiesterase TDP1 are involved in independent pathways of DNA-protein crosslink repair in plants. Plant Cell 2019, 31, 775–790. [Google Scholar] [CrossRef] [PubMed]
- Liu, C.; Pouliot, J.J.; Nash, H.A. The role of TDP1 from budding yeast in the repair of DNA damage. DNA Repair (Amst.) 2004, 3, 593–601. [Google Scholar] [CrossRef] [PubMed]
- Anticevic, I.; Otten, C.; Vinkovic, L.; Jukic, L.; Popovic, M. Tyrosyl-DNA phosphodiesterase 1 (TDP1) and SPRTN protease repair histone 3 and topoisomerase 1 DNA-protein crosslinks in vivo. Open Biol. 2023, 13, 230113. [Google Scholar] [CrossRef] [PubMed]
- Mutti, G.; Raveane, A.; Pagano, A.; Bertolini, F.; Semino, O.; Balestrazzi, A.; Macovei, A. Plant TDP1 (Tyrosyl-DNA Phosphodiesterase 1): A phylogenetic perspective and gene expression data mining. Genes 2020, 11, 1465. [Google Scholar] [CrossRef] [PubMed]
- Lee, S.Y.; Kim, H.; Hwang, H.J.; Jeong, Y.M.; Na, S.H.; Woo, J.C.; Kim, S.G. Identification of tyrosyl-DNA phosphodiesterase as a novel DNA damage repair enzyme in Arabidopsis. Plant Physiol. 2010, 154, 1460–1469. [Google Scholar] [CrossRef]
- Kim, H.; Na, S.H.; Lee, S.Y.; Jeong, Y.M.; Hwang, H.J.; Hur, J.Y.; Park, S.H.; Woo, J.C.; Kim, S.G. Structure-function studies of a plant tyrosyl-DNA phosphodiesterase provide novel insights into DNA repair mechanisms of Arabidopsis thaliana. Biochem. J. 2012, 443, 49–56. [Google Scholar] [CrossRef] [PubMed]
- Sabatini, M.E.; Pagano, A.; Araùjo, S.; Balestrazzi, A.; Macovei, A. The tyrosyl-DNA phosphodiesterase 1β (Tdp1β) gene discloses an early response to abiotic stresses. Genes 2017, 8, 305. [Google Scholar] [CrossRef] [PubMed]
- Macovei, A.; Pagano, A.; Sabatini, M.E.; Grandi, S.; Balestrazzi, A. The human tyrosyl-DNA phosphodiesterase 1 (hTdp1) inhibitor NSC120686 as an exploratory tool to investigate plant Tdp1 denes. Genes 2018, 9, 186. [Google Scholar] [CrossRef]
- Pagano, P.; Pagano, A.; Paternolli, S.; Balestrazzi, A.; Macovei, A. Integrative transcriptomics data mining to explore the functions of TDP1α and TDP1β genes in the Arabidopsis thaliana model plant. Genes 2023, 4, 884. [Google Scholar] [CrossRef]
- Pagano, P.; Bertoncini, A.; Pagano, A.; Nisa, M.U.; Raynaud, C.; Balestrazzi, A.; Macovei, A. Exposure of Arabidopsis thalian mutants to genotoxic stress provides new insights for the involvement of TDP1α and TDP1β genes in DNA damage response. Plant Cell Environ. 2024, 47, 5483–5497. [Google Scholar] [CrossRef] [PubMed]
- Weidlich, I.E.; Dexheimer, T.S.; Marchand, C.; Antony, S.; Pommier, Y.; Nicklaus, M.C. Virtual screening using ligand-based pharmacophores for inhibitors of human Tyrosyl-DNA Phospodiesterase (hTdp1). Bioorg. Med. Chem. 2010, 6, 2347–2355. [Google Scholar] [CrossRef] [PubMed][Green Version]
- Yin, H.; Zhang, X.; Liu, J.; Wang, Y.; He, J.; Yang, T.; Hong, X.; Yang, Q.; Gong, Z. Epigenetic regulation, somatic homologous recombination, and abscisic acid signaling are influenced by DNA polymerase epsilon mutation in Arabidopsis. Plant Cell 2009, 21, 386–402. [Google Scholar] [CrossRef] [PubMed]
- Ranal, M.A.; Garcia de Santana, D. How and why to measure the germination process? Braz. J. Bot. 2006, 29, 1–11. [Google Scholar] [CrossRef]
- Czechowski, T.; Stitt, M.; Altmann, T.; Udvardi, M.K.; Scheible, W.R. Genome-wide identification and testing of superior reference genes for transcript normalization in Arabidopsis. Plant Physiol. 2005, 139, 5–17. [Google Scholar] [CrossRef] [PubMed]
- Pfaffl, M.W. A new mathematical model for relative quantification in real-time RT-PCR. Nucl. Acids Res. 2001, 29, e45. [Google Scholar] [CrossRef] [PubMed]
- De Rybel, B.; Audenaert, D.; Vert, G.; Rozhon, W.; Mayerhofer, J.; Peelman, F.; Coutuer, S.; Denayer, T.; Jansen, L.; Nguyen, L.; et al. Chemical inhibition of a subset of Arabidopsis thaliana GSK3-like kinases activates brassinosteroid signaling. Chem. Biol. 2009, 16, 594–604. [Google Scholar] [CrossRef]
- Dow, L.; Barrow, R.A.; White, R.G.; Mathesius, U. Photolysis of caged cytokinin in single cells of Arab. Thaliana. Plant Methods. 2022, 18, 120. [Google Scholar] [CrossRef]
- Liu, R.; Liang, G.; Gong, J.; Wang, J.; Zhang, Y.; Hao, Z.; Li, G. A potential ABA analog to increase drought tolerance in Arabidopsis thaliana. Int. J. Mol. Sci. 2023, 24, 8783. [Google Scholar] [CrossRef]
- Zwicker, F.; Hauswald, H.; Debus, J.; Huber, P.E.; Weber, K.J. Impact of dimethyl sulfoxide on irradiation-related DNA double-strand-break induction, -repair and cell survival. Radiat. Environ. Biophys. 2019, 58, 417–424. [Google Scholar] [CrossRef] [PubMed]
- Chan, C.-C.; Hsiao, Y.-Y. The effects of dimethylsulfoxide and oxygen on DNA damage induction and repair outcomes for cells irradiated by 62 MeV proton and 3.31 MeV helium ions. J. Pers. Med. 2021, 11, 286. [Google Scholar] [CrossRef] [PubMed]
- Sangweni, N.F.; Dludla, P.V.; Chellan, N.; Mabasa, L.; Sharma, J.R.; Johnson, R. The implication of low dose dimethyl sulfoxide on mitochondrial function and oxidative damage in cultured cardiac and cancer cells. Molecules 2021, 26, 7305. [Google Scholar] [CrossRef] [PubMed]
- Erdman, H.E.; Hsieh, J.J.S. Dimethylsulfoxide (DMSO) effects on four economically important crops. Agron. J. 1969, 61, 528–530. [Google Scholar] [CrossRef]
- Valencia-Quintana, R.; Gómez-Arroyo, S.; Waliszewski, S.M.; Sánchez-Alarcón, J.; Gómez-Olivares, J.L.; Flores-Márquez, A.R.; Cortés-Eslava, J.; Villalobos-Pietrini, R. Evaluation of the genotoxic potential of dimethyl sulfoxide (DMSO) in meristematic cells of the root of Vicia Faba. Toxicol. Environ. Health Sci. 2012, 4, 154–160. [Google Scholar] [CrossRef]
- Gualtieri, C.; Gianella, M.; Pagano, A.; Cadeddu, T.; Araújo, S.; Balestrazzi, A.; Macovei, A. Exploring microRNA signatures of DNA damage response using an innovative system of genotoxic stress in Medicago truncatula seedlings. Front. Plant Sci. 2021, 12, 645323. [Google Scholar] [CrossRef] [PubMed]
- Ryu, T.H.; Kim, J.K.; Kim, J.I.; Kim, J.H. Transcriptome-based biological dosimetry of gamma radiation in Arabidopsis using DNA damage response genes. J. Environ. Radioact. 2018, 181, 94–101. [Google Scholar] [CrossRef] [PubMed]
- Sakamoto, A.N.; Sakamoto, T.; Yokota, Y.; Teranishi, M.; Yoshiyama, K.O.; Kimura, S. SOG1, a plant-specific master regulator of DNA damage responses, originated from nonvascular land plants. Plant Direct. 2021, 5, e370. [Google Scholar] [CrossRef] [PubMed]
- Li, J.; Qian, W. Translational control of SOG1 expression in response to replication stress in Arabidopsis. Stress Biol. 2023, 3, 28. [Google Scholar] [CrossRef]
- Perego, P.; Cossa, G.; Tinelli, S.; Corna, E.; Carenini, N.; Gatti, L.; De Cesare, M.; Ciusani, E.; Zunino, F.; Luison, E.; et al. Role of tyrosyl-DNA phosphodiesterase 1 and inter-players in regulation of tumor cell sensitivity to topoisomerase I inhibition. Biochem. Pharmacol. 2012, 83, 27–36. [Google Scholar] [CrossRef]
- Li, Q.; Zhou, J.; Li, S.; Zhang, W.; Du, Y.; Li, K.; Wang, Y.; Sun, Q. DNA polymerase ε harmonizes topological states and R-loops formation to maintain genome integrity in Arabidopsis. Nat. Commun. 2023, 14, 7763. [Google Scholar] [CrossRef]
- Hertzberg, R.P.; Busby, R.W.; Caranfa, M.J.; Holden, K.G.; Johnson, R.K.; Hecht, S.M.; Kingsbury, W.D. Irreversible trapping of the DNA-topoisomerase I covalent complex. Affinity labeling of the camptothecin binding site. J. Biol. Chem. 1990, 265, 19287–19295. [Google Scholar] [CrossRef] [PubMed]
- Pommier, Y.; Kohlhagen, G.; Kohn, K.W.; Leteurtre, F.; Wani, M.C.; Wall, M.E. Interaction of an alkylating camptothecin derivative with a DNA base at topoisomerase I-DNA cleavage sites. Proc. Natl. Acad. Sci. USA 1995, 92, 8861–8865. [Google Scholar] [CrossRef]
- Wright, C.M.; van der Merwe, M.; DeBrot, A.H.; Bjornsti, M.A. DNA topoisomerase I domain interactions impact enzyme activity and sensitivity to camptothecin. J. Biol. Chem. 2015, 290, 12068–12078. [Google Scholar] [CrossRef]
- Sánchez-Pons, N.; Irar, S.; García-Muniz, N.; Vicient, C.M. Transcriptomic and proteomic profiling of maize embryos exposed to camptothecin. BMC Plant Biol. 2011, 11, 91. [Google Scholar] [CrossRef]
- Shafiq, S.; Chen, C.; Yang, J.; Cheng, L.; Ma, F.; Widemann, E.; Sun, Q. DNA topoisomerase 1 prevents R-loop accumulation to modulate auxin-regulated root development in rice. Mol. Plant. 2017, 10, 821–833. [Google Scholar] [CrossRef] [PubMed]
- Forti, C.; Ottobrino, V.; Bassolino, L.; Toppino, L.; Rotino, G.L.; Pagano, A.; Macovei, A.; Balestrazzi, A. Molecular dynamics of pre-germinative metabolism in primed eggplant (Solanum melongena L.) seeds. Hortic. Res. 2020, 7, 87. [Google Scholar] [CrossRef]
- Dang, P.; Patel, J.; Sorensen, R.; Lamb, M.; Chen, C.Y. Genome-wide association analysis identified Quantitative Trait Loci (QTLs) underlying drought-related traits in cultivated peanut (Arachis hypogaea L.). Genes 2024, 15, 868. [Google Scholar] [CrossRef] [PubMed]
- Lamaoui, M.; Jemo, M.; Datla, R.; Bekkaoui, F. Heat and drought stresses in crops and approaches for their mitigation. Front. Chem. 2018, 6, 26. [Google Scholar] [CrossRef]
- Villalobos-López, M.A.; Arroyo-Becerra, A.; Quintero-Jiménez, A.; Iturriaga, G. Biotechnological advances to improve abiotic stress tolerance in crops. Int. J. Mol. Sci. 2022, 23, 12053. [Google Scholar] [CrossRef] [PubMed]
- Şimşek, Ö.; Isak, M.A.; Dönmez, D.; Dalda Şekerci, A.; İzgü, T.; Kaçar, Y.A. Advanced biotechnological interventions in mitigating drought stress in plants. Plants 2024, 13, 717. [Google Scholar] [CrossRef] [PubMed]

| DMSO | NSC | CPT | |
|---|---|---|---|
| col0 | B | B | R |
| sog1 | R | ||
| pol2a | F, B | B | F, R |
| e2fb | B | B | R |
| sog1/pol2a | F, B | F, R | |
| pol2a/e2fb | F, B | F, B | F, R, O |
| e2fb/sog1 | B | B | R |
| atm | B | R | R |
| atr | B | B | R |
Disclaimer/Publisher’s Note: The statements, opinions and data contained in all publications are solely those of the individual author(s) and contributor(s) and not of MDPI and/or the editor(s). MDPI and/or the editor(s) disclaim responsibility for any injury to people or property resulting from any ideas, methods, instructions or products referred to in the content. |
© 2025 by the authors. Licensee MDPI, Basel, Switzerland. This article is an open access article distributed under the terms and conditions of the Creative Commons Attribution (CC BY) license (https://creativecommons.org/licenses/by/4.0/).
Share and Cite
Bertoncini, A.; Pagano, P.; Macovei, A. Arabidopsis thaliana DNA Damage Response Mutants Challenged with Genotoxic Agents—A Different Experimental Approach to Investigate the TDP1α and TDP1β Genes. Genes 2025, 16, 103. https://doi.org/10.3390/genes16010103
Bertoncini A, Pagano P, Macovei A. Arabidopsis thaliana DNA Damage Response Mutants Challenged with Genotoxic Agents—A Different Experimental Approach to Investigate the TDP1α and TDP1β Genes. Genes. 2025; 16(1):103. https://doi.org/10.3390/genes16010103
Chicago/Turabian StyleBertoncini, Anna, Paola Pagano, and Anca Macovei. 2025. "Arabidopsis thaliana DNA Damage Response Mutants Challenged with Genotoxic Agents—A Different Experimental Approach to Investigate the TDP1α and TDP1β Genes" Genes 16, no. 1: 103. https://doi.org/10.3390/genes16010103
APA StyleBertoncini, A., Pagano, P., & Macovei, A. (2025). Arabidopsis thaliana DNA Damage Response Mutants Challenged with Genotoxic Agents—A Different Experimental Approach to Investigate the TDP1α and TDP1β Genes. Genes, 16(1), 103. https://doi.org/10.3390/genes16010103

